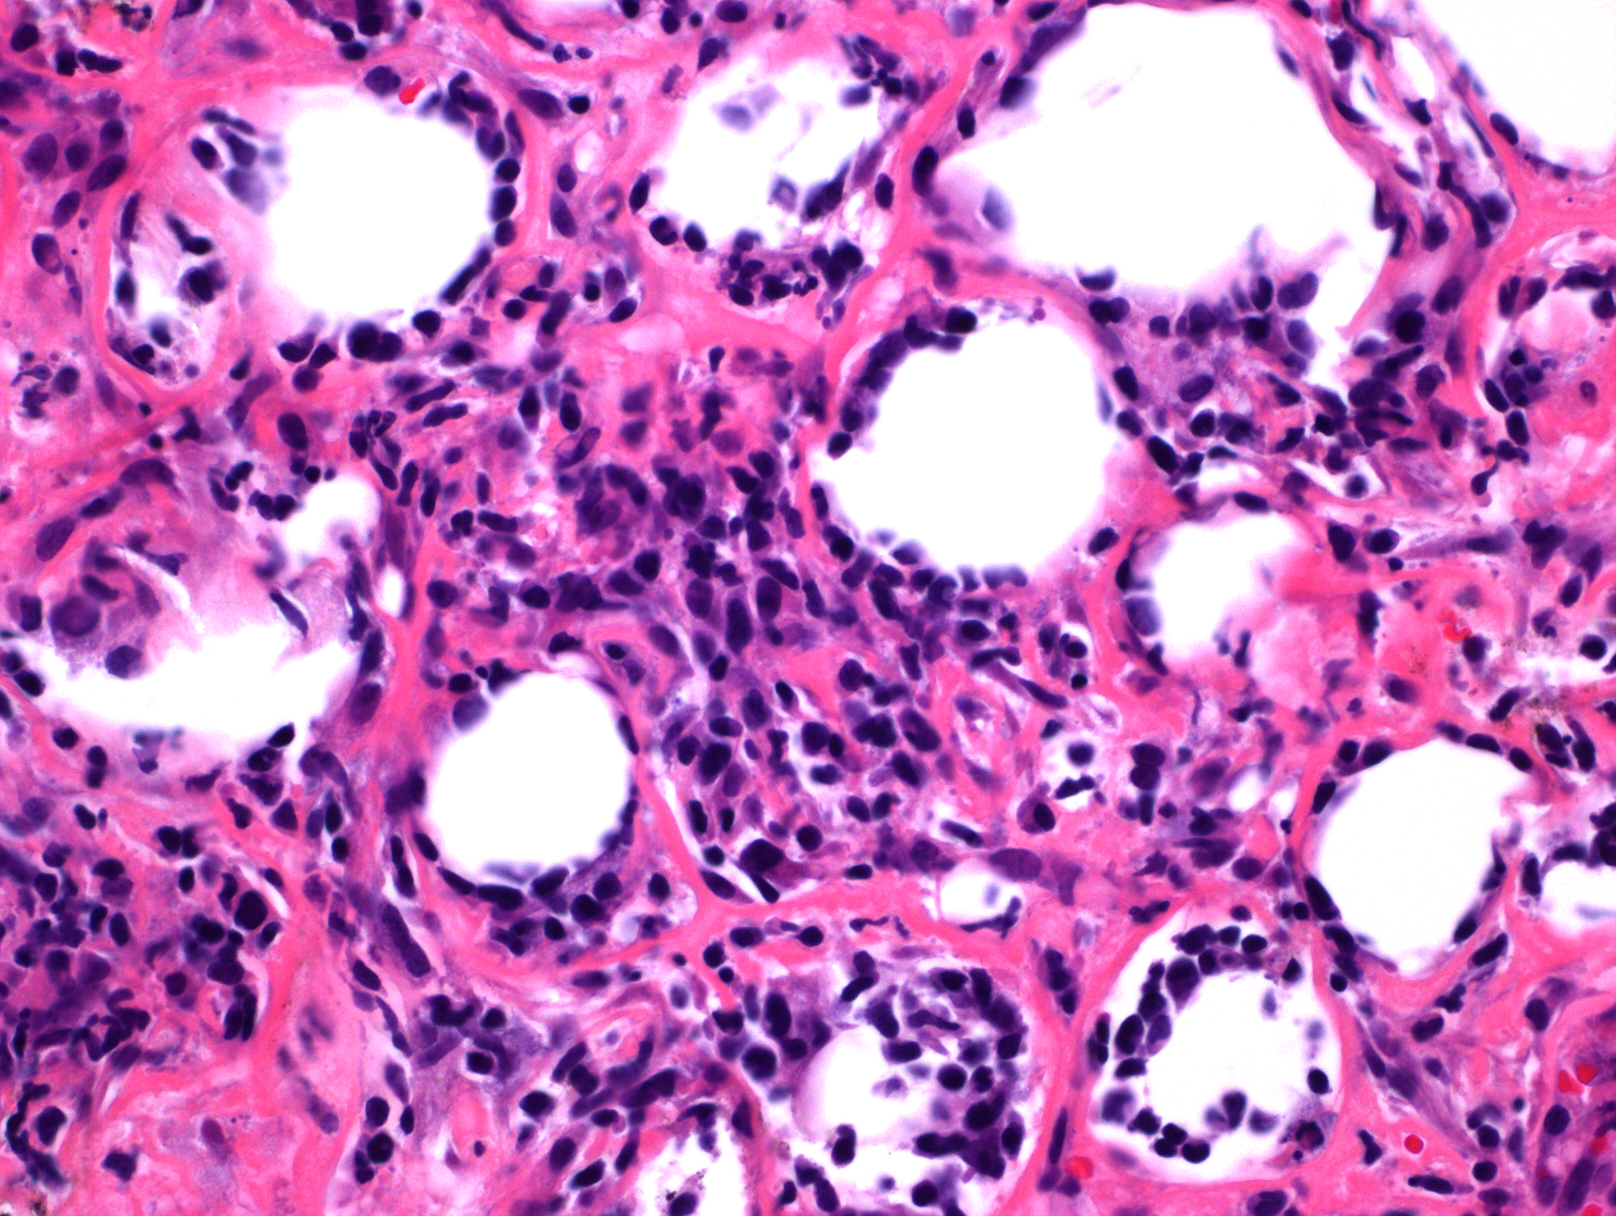

皮下脂膜炎样 T 细胞淋巴瘤
Subcutaneous Panniculitis-Like T-Cell Lymphoma, SPTCL
概述:
SPTCL 是一种成熟 T 细胞淋巴瘤,侵犯皮下脂肪组织,形成脂膜炎样病变,经常伴有脂肪坏死。肿瘤细胞大小不等,具细胞毒和 αβ 表型。同样累及皮下组织的 γδ 表型淋巴瘤另归类为原发性皮肤 γ/δT 细胞淋巴瘤(PCGD-TCL)。
诊断要点:
成年和儿童均可发病,中位年龄 35 岁(20%病例小于 20 岁)。通常累及下肢、躯干或上肢,表现为多发性皮下结节或斑块。淋巴节一般不大,骨髓罕见累及。50%病例可出现全身症状,少数病例(15-20%)并发嗜血细胞增多症,肝脾肿大。
肿瘤细胞主要累及皮下组织,呈现密集侵润,常见具特征性的环绕单个脂肪细胞生长。脂肪坏死常见,血管也可受累,但一般不呈现血管中心性侵润模式。
肿瘤细胞大小以病例而定,通常小到中等,也可中到大,但具体某一病例细胞大小较一致,核不规则深染。常混有组织细胞,甚至形成局部肉芽肿样改变,其它炎性细胞(如浆细胞)缺乏或罕见。
免疫表型:肿瘤细胞 CD3+,通常 CD8+/CD4-,细胞毒分子+,βF1+,TCR-δ1-,CD56-
TCR 基因克隆性重排。

鉴别诊断:
- 母细胞性浆细胞样树突细胞肿瘤 (BPDCN):累及皮肤时,通常呈现弥漫真皮浸润,可延至皮下,一般不环绕脂肪细胞生长,细胞核染色质细腻,除表达 CD4 和 CD56 外,还表达 CD123 和 TCL1。
- 狼疮性脂膜炎 :累及真皮及皮下,侵润淋巴细胞异形性不显著,有时可见生发中心,常混有组织细胞及浆细胞, 皮下组织常有黏液物质沉积。免疫表型为 T 细胞,混合 CD4 和 CD8,并同时有较多 B 细胞。患者有自身免疫病史。需注意的是,部分 SPTCL 病例也有自身免疫疾病包括狼疮脂膜炎病史。
- 原发性皮肤 γ/δT 细胞淋巴瘤 (Primary Cutaneous γ/δT Cell Lymphoma):临床表现为侵袭性,肿瘤主要侵犯四肢可也累及全身皮肤和内脏。肿瘤细胞可浸润表皮、真皮或皮下,表达 CD3. CD56. CD2. TCRδ,不表达 CD4. CD8(少数+)、CD5. βF1。
- 淋巴瘤样丘疹病 (LyP):低倍镜下淋巴细胞浸润范围常成楔形,临床表现为同时存在丘疹、丘疹性坏死、结节这些不同阶段的皮肤病变,单个病变会存在数周至数月然后自行消失,留下浅表疤痕。浸润淋巴细胞一般 CD30+、CD4+、CD8-(D 型 CD8+)。
